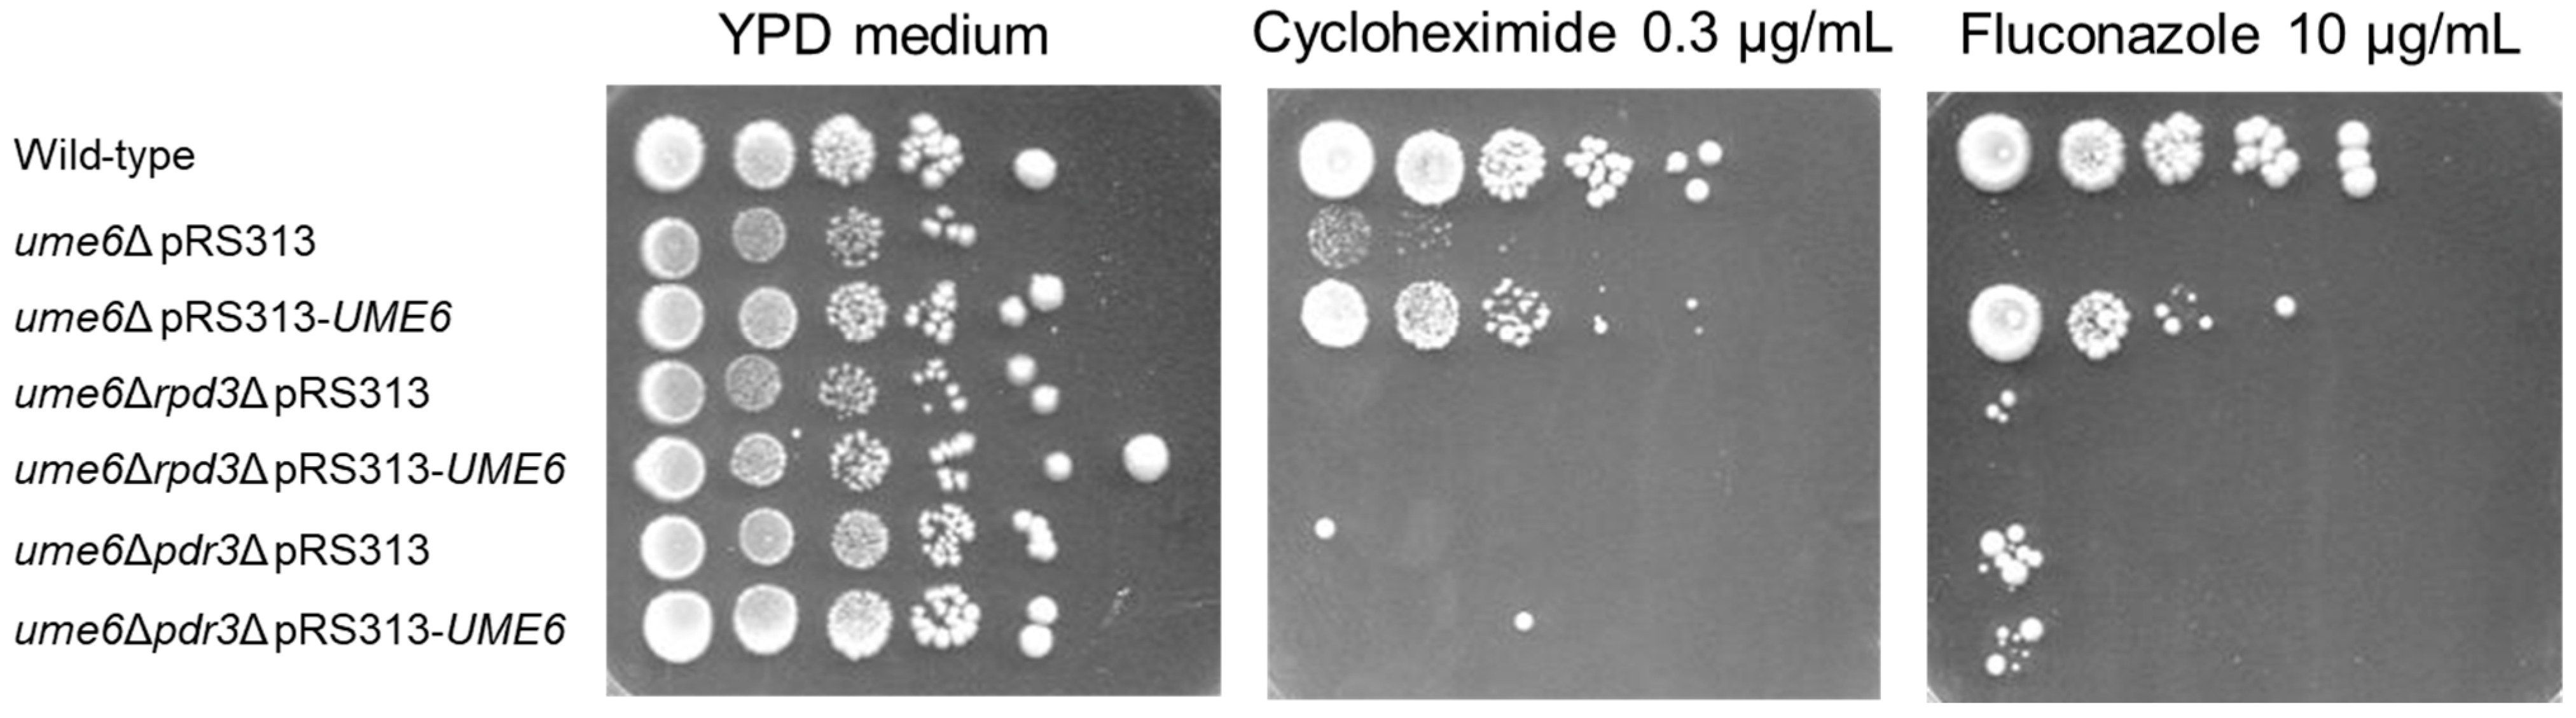
Microbiolres 15 00048 g004

In Saccharomyces cerevisiae ρ0 Cells, UME6 Contributes to the Activation of ABC Transporter Genes and Pleiotropic Drug Resistance via RPD3 and PDR3
Abstract
:1. Introduction
2. Materials and Methods
2.1. Yeast Strains, Plasmids, and Media
2.2. Spot Dilution Assay
2.3. RNA Extraction from ρ0 Cells of Each Yeast Strain Grown to the Logarithmic Growth Phase
2.4. Real-Time RT–PCR
2.5. Statistical Analysis
3. Results
3.1. UME6 and RPD3 Are Required for the Upregulation of the Steady-State mRNA Levels of SNQ2, PDR15, and PDR5 in ρ0 Cells
3.2. RPD3 and PDR3 Are Required for the Partial Rescue of the Reduction in PDR15 and PDR5 Expression in the ume6Δ Strain by Exogeneous UME6 Expression
3.3. RPD3 and PDR3 Are Required for Incomplete Restoration of Susceptibility to Fluconazole and Cycloheximide in the ume6Δ Strain via Exogeneous UME6 Expression
4. Discussion
5. Conclusions
Supplementary Materials
Author Contributions
Funding
Institutional Review Board Statement
Informed Consent Statement
Data Availability Statement
Acknowledgments
Conflicts of Interest
References
- Khunweeraphong, N.; Kuchler, K. Multidrug Resistance in Mammals and Fungi—From MDR to PDR: A Rocky Road from Atomic Structures to Transport Mechanisms. Int. J. Mol. Sci. 2021, 22, 4806. [Google Scholar] [CrossRef] [PubMed]
- Catalano, A.; Iacopetta, D.; Ceramella, J.; Scumaci, D.; Giuzio, F.; Saturnino, C.; Aquaro, S.; Rosano, C.; Sinicropi, M.S. Multidrug Resistance (MDR): A Widespread Phenomenon in Pharmacological Therapies. Molecules 2022, 27, 616. [Google Scholar] [CrossRef] [PubMed]
- Chang, Y.C.; Shieh, M.C.; Chang, Y.H.; Huang, W.L.; Su, W.C.; Cheng, F.Y.; Cheung, C.H.A. Development of a cancer cells self-activating and miR-125a-5p expressing poly-pharmacological nanodrug for cancer treatment. Int. J. Mol. Med. 2022, 50, 102. [Google Scholar] [CrossRef]
- Karthika, C.; Sureshkumar, R.; Zehravi, M.; Akter, R.; Ali, F.; Ramproshad, S.; Mondal, B.; Tagde, P.; Ahmed, Z.; Khan, F.S.; et al. Multidrug Resistance of Cancer Cells and the Vital Role of P-Glycoprotein. Life 2022, 12, 897. [Google Scholar] [CrossRef] [PubMed]
- Singh, S.; Gomez, H.J.; Thakkar, S.; Singh, S.P.; Parihar, A.S. Overcoming Acquired Drug Resistance to Cancer Therapies through Targeted STAT3 Inhibition. Int. J. Mol. Sci. 2023, 24, 4722. [Google Scholar] [CrossRef] [PubMed]
- Berman, J.; Krysan, D.J. Drug resistance and tolerance in fungi. Nat. Rev. Microbiol. 2020, 18, 319–331. [Google Scholar] [CrossRef] [PubMed]
- Osset-Trénor, P.; Pascual-Ahuir, A.; Proft, M. Fungal Drug Response and Antimicrobial Resistance. J. Fungi 2023, 9, 565. [Google Scholar] [CrossRef]
- Czajka, K.M.; Venkataraman, K.; Brabant-Kirwan, D.; Santi, S.A.; Verschoor, C.; Appanna, V.D.; Singh, R.; Saunders, D.P.; Tharmalingam, S. Molecular Mechanisms Associated with Antifungal Resistance in Pathogenic Candida Species. Cells 2023, 12, 2655. [Google Scholar] [CrossRef] [PubMed]
- Oyama, M.; Tamaki, H.; Yamaguchi, Y.; Ogita, A.; Tanaka, T.; Fujita, K.I. Deletion of the Golgi Ca2+-ATPase PMR1 gene potentiates antifungal effects of dodecanol that depend on intracellular Ca2+ accumulation in budding yeast. FEMS Yeast Res. 2020, 20, foaa003. [Google Scholar] [CrossRef]
- Song, J.; Zhou, J.; Zhang, L.; Li, R. Mitochondria-Mediated Azole Drug Resistance and Fungal Pathogenicity: Opportunities for Therapeutic Development. Microorganisms 2020, 8, 1574. [Google Scholar] [CrossRef]
- Demuyser, L.; Van Dijck, P. Can Saccharomyces cerevisiae keep up as a model system in fungal azole susceptibility research? Drug Resist. Updat. 2019, 42, 22–34. [Google Scholar] [CrossRef] [PubMed]
- Zhang, X.; Moye-Rowley, W.S. Saccharomyces cerevisiae multidrug resistance gene expression inversely correlates with the status of the F0 Component of the mitochondrial ATPase. J. Biol. Chem. 2001, 276, 47844–47852. [Google Scholar] [CrossRef] [PubMed]
- Decottignies, A.; Grant, A.M.; Nichols, J.W.; de Wet, H.; McIntosh, D.B.; Goffeau, A. ATPase and multidrug transport activities of the overexpressed yeast ABC protein Yor1p. J. Biol. Chem. 1998, 273, 12612–12622. [Google Scholar] [CrossRef] [PubMed]
- Carvajal, E.; Van Den Hazel, H.B.; Cybularz-Kolaczkowska, A.; Balzi, E.; Goffeau, A. Molecular and phenotypic: Characterization of yeast PDR1 mutants that show hyperactive transcription of various ABC multidrug transporter genes. Mol. Gen. Genet. 1997, 256, 406–415. [Google Scholar] [CrossRef] [PubMed]
- Nourani, A.; Wesolowski-Louvel, M.; Delaveau, T.; Jacq, C.; Delahodde, A. Multiple-drug-resistance phenomenon in the yeast Saccharomyces cerevisiae: Involvement of two hexose transporters. Mol. Cell Biol. 1997, 17, 5453–5460. [Google Scholar] [CrossRef] [PubMed]
- Cui, Z.; Hirata, D.; Tsuchiya, E.; Osada, H.; Miyakawa, T. The multidrug resistance-associated protein (MRP) subfamily (Yrs1/Yor1) of Saccharomyces cerevisiae is important for the tolerance to a broad range of organic anions. J. Biol. Chem. 1996, 271, 14712–14716. [Google Scholar] [CrossRef] [PubMed]
- Mahé, Y.; Lemoine, Y.; Kuchler, K. The ATP binding cassette transporters Pdr5 and Snq2 of Saccharomyces cerevisiae can mediate transport of steroids in vivo. J. Biol. Chem. 1996, 271, 25167–25172. [Google Scholar] [CrossRef] [PubMed]
- Balzi, E.; Wang, M.; Leterme, S.; Van Dyck, L.; Goffeau, A. PDR5, a novel yeast multidrug resistance conferring transporter controlled by the transcription regulator PDR1. J. Biol. Chem. 1994, 269, 2206–2214. [Google Scholar] [CrossRef] [PubMed]
- Ueda, Y.; Tahara, Y.O.; Miyata, M.; Ogita, A.; Yamaguchi, Y.; Tanaka, T.; Fujita, K.I. Involvement of a Multidrug Efflux Pump and Alterations in Cell Surface Structure in the Synergistic Antifungal Activity of Nagilactone E and Anethole against Budding Yeast Saccharomyces cerevisiae. Antibiotics 2021, 10, 537. [Google Scholar] [CrossRef]
- Wolfger, H.; Mahé, Y.; Parle-McDermott, A.; Delahodde, A.; Kuchler, K. The yeast ATP binding cassette (ABC) protein genes PDR10 and PDR15 are novel targets for the Pdr1 and Pdr3 transcriptional regulators. FEBS Lett. 1997, 418, 269–274. [Google Scholar] [CrossRef]
- Katzmann, D.J.; Hallstrom, T.C.; Mahé, Y.; Moye-Rowley, W.S. Multiple Pdr1p/Pdr3p binding sites are essential for normal expression of the ATP binding cassette transporter protein-encoding gene PDR5. J. Biol. Chem. 1996, 271, 23049–23054. [Google Scholar] [CrossRef] [PubMed]
- Delahodde, A.; Delaveau, T.; Jacq, C. Positive autoregulation of the yeast transcription factor Pdr3p, which is involved in control of drug resistance. Mol. Cell. Biol. 1995, 15, 4043–4051. [Google Scholar] [CrossRef] [PubMed]
- Delaveau, T.; Delahodde, A.; Carvajal, E.; Subik, J.; Jacq, C. PDR3, a new yeast regulatory gene, is homologous to PDR1 and controls the multidrug resistance phenomenon. Mol. Gen. Genet. 1994, 244, 501–511. [Google Scholar] [CrossRef]
- DeRisi, J.; van den Hazel, B.; Marc, P.; Balzi, E.; Brown, P.; Jacq, C.; Goffeau, A. Genome microarray analysis of transcriptional activation in multidrug resistance yeast mutants. FEBS Lett. 2000, 470, 156–160. [Google Scholar] [CrossRef]
- Plocek, V.; Fadrhonc, K.; Maršíková, J.; Váchová, L.; Pokorná, A.; Hlaváček, O.; Wilkinson, D.; Palková, Z. Mitochondrial Retrograde Signaling Contributes to Metabolic Differentiation in Yeast Colonies. Int. J. Mol. Sci. 2021, 22, 5597. [Google Scholar] [CrossRef] [PubMed]
- Gorospe, C.M.; Carvalho, G.; Herrera Curbelo, A.; Marchhart, L.; Mendes, I.C.; Niedźwiecka, K.; Wanrooij, P.H. Mitochondrial membrane potential acts as a retrograde signal to regulate cell cycle progression. Life Sci. Alliance 2023, 6, e202302091. [Google Scholar] [CrossRef]
- Hallstrom, T.C.; Moye-Rowley, W.S. Multiple signals from dysfunctional mitochondria activate the pleiotropic drug resistance pathway in Saccharomyces cerevisiae. J. Biol. Chem. 2000, 275, 37347–37356. [Google Scholar] [CrossRef]
- Shahi, P.; Gulshan, K.; Moye-Rowley, W.S. Negative transcriptional regulation of multidrug resistance gene expression by an Hsp70 protein. J. Biol. Chem. 2007, 282, 26822–26831. [Google Scholar] [CrossRef]
- Shahi, P.; Gulshan, K.; Näär, A.M.; Moye-Rowley, W.S. Differential Roles of Transcriptional Mediator Subunits in Regulation of Multidrug Resistance Gene Expression in Saccharomyces cerevisiae. Mol. Biol. Cell 2010, 21, 2469–2482. [Google Scholar] [CrossRef]
- Gulshan, K.; Schmidt, J.A.; Shahi, P.; Moye-Rowley, W.S. Evidence for the bifunctional nature of mitochondrial phosphatidylserine decarboxylase: Role in Pdr3-dependent retrograde regulation of PDR5 expression. Mol. Cell Biol. 2008, 28, 5851–5864. [Google Scholar] [CrossRef]
- Zhang, X.; Kolaczkowska, A.; Devaux, F.; Panwar, S.L.; Hallstrom, T.C.; Jacq, C.; Moye-Rowley, W.S. Transcriptional regulation by Lge1p requires a function independent of its role in histone H2B ubiquitination. J. Biol. Chem. 2005, 280, 2759–2770. [Google Scholar] [CrossRef] [PubMed]
- Paul, S.; Moye-Rowley, W.S. Multidrug resistance in fungi: Regulation of transporter-encoding gene expression. Front. Physiol. 2014, 5, 143. [Google Scholar] [CrossRef]
- Robbins, N.; Leach, M.D.; Cowen, L.E. Lysine Deacetylases Hda1 and Rpd3 Regulate Hsp90 Function thereby Governing Fungal Drug Resistance. Cell Rep. 2012, 2, 878–888. [Google Scholar] [CrossRef] [PubMed]
- Rundlett, S.E.; Carmen, A.A.; Suka, N.; Turner, B.M.; Grunstein, M. Transcriptional repression by UME6 involves deacetylation of lysine 5 of histone H4 by RPD3. Nature 1998, 392, 831–835. [Google Scholar] [CrossRef] [PubMed]
- Goldmark, J.P.; Fazzio, T.G.; Estep, P.W.; Church, G.M.; Tsukiyama, T. The Isw2 chromatin remodeling complex represses early meiotic genes upon recruitment by Ume6p. Cell 2000, 103, 423–433. [Google Scholar] [CrossRef] [PubMed]
- Patel, A.B.; Qing, J.; Tam, K.H.; Zaman, S.; Luiso, M.; Radhakrishnan, I.; He, Y. Cryo-EM structure of the Saccharomyces cerevisiae Rpd3L histone deacetylase complex. Nat. Commun. 2023, 14, 3061. [Google Scholar] [CrossRef] [PubMed]
- Carrozza, M.J.; Florens, L.; Swanson, S.K.; Shia, W.J.; Anderson, S.; Yates, J.; Washburn, M.P.; Workman, J.L. Stable incorporation of sequence specific repressors Ash1 and Ume6 into the Rpd3L complex. Biochim. Biophys. Acta 2005, 1731, 77–87. [Google Scholar] [CrossRef] [PubMed]
- David, K.; Kevin, S. Repression by Ume6 involves recruitment of a complex containing Sin3 corepressor and Rpd3 histone deacetylase to target promoters. Cell 1997, 89, 365–371. [Google Scholar]
- Strich, R.; Surosky, R.T.; Steber, C.; Dubois, E.; Messenguy, F.; Esposito, R.E. UME6 is a key regulator of nitrogen repression and meiotic development. Genes Dev. 1994, 8, 796–810. [Google Scholar] [CrossRef]
- Fazzio, T.G.; Kooperberg, C.; Goldmark, J.P.; Neal, C.; Basom, R.; Delrow, J.; Tsukiyama, T. Widespread collaboration of Isw2 and Sin3-Rpd3 chromatin remodeling complexes in transcriptional repression. Mol. Cell Biol. 2001, 21, 6450–6460. [Google Scholar] [CrossRef]
- Kadosh, D.; Struhl, K. Targeted recruitment of the Sin3-Rpd3 histone deacetylase complex generates a highly localized domain of repressed chromatin in vivo. Mol. Cell Biol. 1998, 18, 5121–5127. [Google Scholar] [CrossRef] [PubMed]
- Harris, A.; Ünal, E. The transcriptional regulator Ume6 is a major driver of early gene expression during gametogenesis. Genetics 2023, 225, iyad123. [Google Scholar] [CrossRef]
- De Nadal, E.; Zapater, M.; Alepuz, P.M.; Sumoy, L.; Mas, G.; Posas, F. The MAPK Hog1 recruits Rpd3 histone deacetylase to activate osmoresponsive genes. Nature 2004, 427, 370–374. [Google Scholar] [CrossRef]
- Sertil, O.; Vemula, A.; Salmon, S.L.; Morse, R.H.; Lowry, C.V. Direct role for the Rpd3 complex in transcriptional induction of the anaerobic DAN/TIR genes in yeast. Mol. Cell Biol. 2007, 27, 2037–2047. [Google Scholar] [CrossRef]
- Yamada, Y. RPD3 and UME6 are involved in the activation of PDR5 transcription and pleiotropic drug resistance in ρ0 cells of Saccharomyces cerevisiae. BMC Microbiol. 2021, 21, 311. [Google Scholar] [CrossRef]
- Yamada, Y. UME6 Is Involved in the Suppression of Basal Transcription of ABC Transporters and Drug Resistance in the ρ+ Cells of Saccharomyces cerevisiae. Microorganisms 2022, 10, 601. [Google Scholar] [CrossRef] [PubMed]
- Onda, M.; Ota, K.; Chiba, T.; Sakaki, Y.; Ito, T. Analysis of gene network regulating yeast multidrug resistance by artificial activation of transcription factors: Involvement of Pdr3 in salt tolerance. Gene 2004, 332, 51–59. [Google Scholar] [CrossRef] [PubMed]
- Czarnecka, M.; Połomska, X.; Restuccia, C.; Żarowska, B. The Role of Plasma Membrane Pleiotropic Drug Resistance Transporters in the Killer Activity of Debaryomyces hansenii and Wickerhamomyces anomalus Toxins. Toxins 2022, 14, 180. [Google Scholar] [CrossRef]
- Yamada, Y.; Shiroma, A.; Hirai, S.; Iwasaki, J. Zuo1, a ribosome-associated J protein, is involved in glucose repression in Saccharomyces cerevisiae. FEMS Yeast Res. 2023, 23, foad038. [Google Scholar] [CrossRef]
- Devaux, F.; Carvajal, E.; Moye-Rowley, S.; Jacq, C. Genome-wide studies on the nuclear PDR3-controlled response to mitochondrial dysfunction in yeast. FEBS Lett. 2002, 515, 25–28. [Google Scholar] [CrossRef]
- Sikorski, R.S.; Hieter, P. A system of shuttle vectors and yeast host strains designed for efficient manipulation of DNA in Saccharomyces cerevisiae. Genetics 1989, 122, 19–27. [Google Scholar] [CrossRef]
- Yamada, Y.; Sasaki, S. A method for identifying allele-specific hydroxymethylation. Epigenetics 2020, 15, 231–250. [Google Scholar] [CrossRef]
- Venters, B.J.; Wachi, S.; Mavrich, T.N.; Andersen, B.E.; Jena, P.; Sinnamon, A.J.; Jain, P.; Rolleri, N.S.; Jiang, C.; Hemeryck-Walsh, C.; et al. A Comprehensive Genomic Binding Map of Gene and Chromatin Regulatory Proteins in Saccharomyces. Mol. Cell 2011, 41, 480–492. [Google Scholar] [CrossRef]
- Nikolov, V.N.; Malavia, D.; Kubota, T. SWI/SNF and the histone chaperone Rtt106 drive expression of the Pleiotropic Drug Resistance network genes. Nat. Commun. 2022, 13, 1968. [Google Scholar] [CrossRef]
- Sharma, V.M.; Tomar, R.S.; Dempsey, A.E.; Reese, J.C. Histone deacetylases RPD3 and HOS2 regulate the transcriptional activation of DNA damage-inducible genes. Mol. Cell Biol. 2007, 27, 3199–3210. [Google Scholar] [CrossRef]
- Prunuske, A.J.; Waltner, J.K.; Kuhn, P.; Gu, B.; Craig, E.A. Role for the molecular chaperones Zuo1 and Ssz1 in quorum sensing via activation of the transcription factor Pdr1. Proc. Natl. Acad. Sci. USA 2012, 109, 472–477. [Google Scholar] [CrossRef]
- Hallstrom, T.C.; Katzmann, D.J.; Torres, R.J.; Sharp, W.J.; Moye-Rowley, W.S. Regulation of transcription factor Pdr1p function by an Hsp70 protein in Saccharomyces cerevisiae. Mol. Cell Biol. 1998, 18, 1147–1155. [Google Scholar] [CrossRef]
- Horvath, R.; Hawe, N.; Lam, C.; Mestnikov, K.; Eji-Lasisi, M.; Rohde, J.; Sadowski, I. TORC1 signaling modulates Cdk8-dependent GAL gene expression in Saccharomyces cerevisiae. Genetics 2021, 219, iyab168. [Google Scholar] [CrossRef]
- Elmlund, H.; Baraznenok, V.; Lindahl, M.; Samuelsen, C.O.; Koeck, P.J.; Holmberg, S.; Hebert, H.; Gustafsson, C.M. The cyclin-dependent kinase 8 module sterically blocks Mediator interactions with RNA polymerase II. Proc. Natl. Acad. Sci. USA 2006, 103, 15788–15793. [Google Scholar] [CrossRef]
- Andrade-Pavón, D.; Sánchez-Sandoval, E.; Tamariz, J.; Ibarra, J.A.; Hernández-Rodríguez, C.; Villa-Tanaca, L. Inhibitors of 3-Hydroxy-3-methylglutaryl Coenzyme A Reductase Decrease the Growth, Ergosterol Synthesis and Generation of petite Mutants in Candida glabrata and Candida albicans. Int. J. Mol. Sci. 2023, 24, 16868. [Google Scholar] [CrossRef]
- Bedekovic, T.; Usher, J. Is There a Relationship Between Mating and Pathogenesis in Two Human Fungal Pathogens, Candida albicans and Candida glabrata? Curr. Clin. Microbiol. Rep. 2023, 10, 47–54. [Google Scholar] [CrossRef]
- Roetzer, A.; Gabaldón, T.; Schüller, C. From Saccharomyces cerevisiae to Candida glabrata in a few easy steps: Important adaptations for an opportunistic pathogen. FEMS Microbiol. Lett. 2011, 314, 1–9. [Google Scholar] [CrossRef] [PubMed]
- Verma, S.; Shakya, V.P.S.; Idnurm, A. Exploring and exploiting the connection between mitochondria and the virulence of human pathogenic fungi. Virulence 2018, 9, 426–446. [Google Scholar] [CrossRef]
- Paul, S.; Schmidt, J.A.; Moye-Rowley, W.S. Regulation of the CgPdr1 transcription factor from the pathogen Candida glabrata. Eukaryot. Cell 2011, 10, 187–197. [Google Scholar] [CrossRef] [PubMed]
- Baker, K.M.; Hoda, S.; Saha, D.; Gregor, J.B.; Georgescu, L.; Serratore, N.D.; Zhang, Y.; Cheng, L.; Lanman, N.A.; Briggs, S.D. The Set1 Histone H3K4 Methyltransferase Contributes to Azole Susceptibility in a Species-Specific Manner by Differentially Altering the Expression of Drug Efflux Pumps and the Ergosterol Gene Pathway. Antimicrob. Agents Chemother. 2022, 66, e0225021. [Google Scholar] [CrossRef]

| Yeast Strain | Genotype | Mitochondrial Genotype | Source or Reference |
|---|---|---|---|
| FY1679-28C | MATa ura3-52 leu2-Δ1 trp1-Δ63 his3-Δ200 GAL2+ | ρ0 | [47] |
| ume6Δ | MATa ume6Δ::bleMX6 ura3-52 leu2-Δ1 trp1-Δ63 his3-Δ200 GAL2+ | ρ0 | [45] |
| ume6rpd3Δ | MAT ume6Δ::bleMX6 rpd3Δ::kanMX ura3-52 leu2-Δ1 trp1-Δ63 his3-Δ200 GAL2+ | ρ0 | This study |
| ume6pdr3Δ | MAT ume6Δ::bleMX6 pdr3Δ::kanMX ura3-52 leu2-Δ1 trp1-Δ63 his3-Δ200 GAL2+ | ρ0 | This study |
Disclaimer/Publisher’s Note: The statements, opinions and data contained in all publications are solely those of the individual author(s) and contributor(s) and not of MDPI and/or the editor(s). MDPI and/or the editor(s) disclaim responsibility for any injury to people or property resulting from any ideas, methods, instructions or products referred to in the content. |
© 2024 by the authors. Licensee MDPI, Basel, Switzerland. This article is an open access article distributed under the terms and conditions of the Creative Commons Attribution (CC BY) license (https://creativecommons.org/licenses/by/4.0/).
Share and Cite
Funasaka, M.; Ota, M.; Yamada, Y. In Saccharomyces cerevisiae ρ0 Cells, UME6 Contributes to the Activation of ABC Transporter Genes and Pleiotropic Drug Resistance via RPD3 and PDR3. Microbiol. Res. 2024, 15, 734-745. https://doi.org/10.3390/microbiolres15020048
Funasaka M, Ota M, Yamada Y. In Saccharomyces cerevisiae ρ0 Cells, UME6 Contributes to the Activation of ABC Transporter Genes and Pleiotropic Drug Resistance via RPD3 and PDR3. Microbiology Research. 2024; 15(2):734-745. https://doi.org/10.3390/microbiolres15020048
Chicago/Turabian StyleFunasaka, Mai, Mahiro Ota, and Yoichi Yamada. 2024. "In Saccharomyces cerevisiae ρ0 Cells, UME6 Contributes to the Activation of ABC Transporter Genes and Pleiotropic Drug Resistance via RPD3 and PDR3" Microbiology Research 15, no. 2: 734-745. https://doi.org/10.3390/microbiolres15020048





